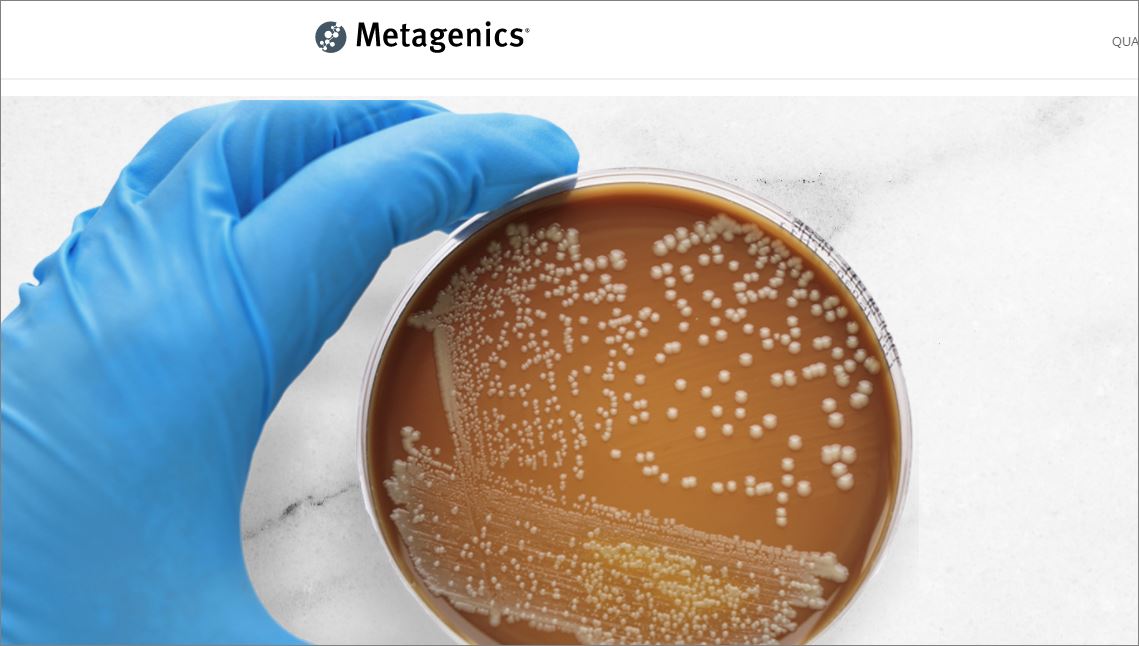

여에스더 유산균 먹어야 하는 이유
여에스더 유산균 먹어야 하는 이유
오늘은 유산균에 관련된 이야기를 하려고 합니다. 소개할 제품은 여에스더 유산균입니다. 저와 여에스더와는 아무 상관이 없고, 단지 이곳의 제품을 애용하는 소비자일 뿐입니다. 굳이 다른 유산균도 많은데 이 제품을 소개하는 이유는 두 가지 이유 때문입니다. 먼저는 가성비이고, 다른 하나는 좋은 유산균이기 때문입니다. 적절한 가격과 좋은 제품이란 점에서 소개합니다. 저희 집은 오랫동안 여에스더 유산균을 먹어왔고 지금도 여전히 종종 먹고 있습니다.

1. 유산균을 먹어야 하는 이유
먼저 유산균을 먹어야 하는 이유에 대해 알아보겠습니다. 우리가 유산균이라고 부르는 정식 명칭은 프로바이오틱스(Probiotics)입니다. 적당량을 섭취할 경우 장내에서 이로운 역할을 하는 세균, 즉 미생물입니다. 우리의 장에는 다양한 균들이 존재합니다. 해로운 균도 있고, 유익한 균도 있습니다. 장에서 대사작용을 통해 다양한 활동을 하게 됩니다. 장에 이로운 균은 대체로 세 부류로 나뉩니다. 유산균(Lactobacillus), 비피더스균(Bifidobacterium), 엔테로콕쿠스(Enterococcus)등이 있는데 이들을 보통 유산균이라고 부릅니다. 물론 일반인들이 그렇게 부른다는 것이죠. 엄밀하게는 다른 균들이지만 하는 일은 거의 동일합니다.
1) 대사작용에 유익합니다.
우리 몸속에는 많은 세균이 존재하는데 무려 80% 정도가 장에 서식합니다. 그만큼 장이 중요하다는 것이죠. 문제는 유익한 균만 서식하지 않고 다양한 질병을 유발하는 해로운 균도 서식한다는 것입니다. 비만과 당뇨, 다양한 질병을 유발하는 균들이 장에 포진하고 있는 것이죠. 장은 끊임없이 세균들이 전쟁하고 있고, 활발한 대사작용을 통해 영양소가 분해되고, 합성되고, 흡수되도록 일을 합니다. 장에 해로운 균이 많게 되면 다양한 질병이 발생하는 원인이 되고 결국 몸은 건강을 해치게 됩니다. 수많은 면역세포들이 장에 포진하는 이유가 바로 그것 때문입니다.
유산균과 같은 유익한 균이 없으면 설사, 배탈, 당뇨, 비만, 독소생성 등의 다양한 질병들이 발생하는 이유가 만들어집니다. 그렇기 때문에 의사들은 배탈이 날 경우 항생제를 주기보다 금식과 유산규를 먹도록 추천하기도 합니다. 이런 의사가 좋은 의사입니다. 항생제를 주는 의사는 ... 하여튼... 그렇습니다. 유산균과 함께 처방하는 것이 좋습니다. 항생제는 나중에 따로 다루도록 하겠습니다.
2) 나이가 들면 장내 유익균이 줄어듭니다.
나이가 많아지면 유산균이 활발하게 활동하지 못하며, 유익한 균이 대체로 줄어듭니다. 그렇기 때문에 나이가 많아질수록 유산균을 먹어주는 것이 건강에 이롭습니다. 학자들은 프로바이오틱스(유산균)을 섭취할 경우 유당불내증을 개선하고, 콜레스테롤 수치를 저하시키고, 혈압을 낮추는 역할도 한다고 말합니다. 그뿐 아니라 면역기능 개선과 염증 예방, 과민성 대장증후군과 결장염 등의 치료효과도 있다고 합니다. 그러니 안 먹는 것보다는 먹는 것이 훨씬 유리하다는 점 말씀드립니다.
2. 시판 중인 유산균의 종류
이제 장내 유산균에 대해 간략하게 알아봅시다. 장에서 활동하는 유익균이 얼마나 되는지 정확하게 알려지지 않았다고 합니다. 현재 국내에서 시판중인 프로바이오틱스 균주는 모두 19가지라고 합니다. 그렇다고 나머지가 나쁘거나 잘못된 것은 아닙니다. 간략하게 정리하면 이렇습니다. 우리가 보통 유산균이라고 부르는 균은 Lactobacillus와 Bifidobacterium입니다.
Lactobacillus균속 11종류
락토바실러스 카제이(L.casei)
락토바실러스 애시도필러스(L.acidophilus)
락토바실러스 델브루에키아 종 불가리쿠스(Lactobacillus delbrueckii ssp bulgaricus)
락토바실러스 헬벡티커스 (Lactobacillus helveticus)
락토바실러스 퍼멘텀 (Lactobacillus fermentum)
락토바실러스 파라카제이 (Lactobacillus paracasei)
락토바실러스 플랜타움 (Lactoabacillus plantarum)
락토바실러스 루테리 (Lactobacillus reuteri)
락토바실러스 람로서스 (Lactobacillus rhamnosus)
락토바실러스 살바리우스 (Lactobacillus salivarius)
Lactococcus균속 1종류
락토코쿠스 클라티스(Lactococcus clatis)
Bifidobacterium 균속 4종류
(우리가 보통 비피더스라고 말하는 균주이며, 여에스서 유산균에 사용되는 유산균입니다.)
비피도박테리움 비피둠(B.bifidum)
비피도박테리움 브레브 (Bifidobacterium breve)
비피도박테리움 롱검 (Bifidobacterium longum)
비피도박테리움 애니멀스종 락티스 (Bifidobacterium animalis ssp. lactis)
Streptococcus균속 1종류
스트렙토코코스 써모필러스 (Streptococcus thermophilus)
Enterococcus균속 2종류
엔테로코커스 패슘 (Enterococcus faecium)
엔테로코커스 페칼리스 (Enterococcus faecalis)
3. 여에스더 유산균의 특징
오늘은 여에스더 유산균에 대해서만 알아봅시다. 제가 추천하는 유산균은 클래식 제품으로 아래 이미지 제품입니다. 물론 다른 것을 섭취하셔도 괜찮습니다.

그 외에도 다양한 제품이 있습니다. 다른 제품들에 대해서는 따로 설명하도록 하겠습니다. 일단 여기서는 클래식 제품만 알아보겠습니다.

여에스더 유산균은 미국 메타제닉스의 완제품을 사용합니다.

메타제닉스(Metagenics)는 미국 캘리포니아 샌 클레멘트에 소재하며 암웨이가 2009년에 인수한 건강식품회사입니다. 유산균 제조의 3대 회사에 들어가면 가장 잘 알려진 회사이기도 합니다.

여에스더 유산균은 100억 균을 제공합니다. 기본적으로 유산균으로서의 보장을 받으려면 10억 균 정도라고 합니다. 100 균이라면 그만큼 좋다는 뜻으로 받으면 될 것 같습니다.

전 과정이 냉장 배송 시스템을 사용합니다. 모든 유산균이 냉장 배송은 아닙니다. 태블릿 형태로 제공되는 ㄷ유산균은 실온 배송이며 실온 저장입니다.
사용 균주는 락토바실러스 애시도필러스 NCFM과 비피도박테리움 락티스 균주인 Bi-07입니다.

더 많은 이유가 있겠지만 가격과 효능 대비 가성비가 높은 제품입니다.
4. 유산균을 먹는 방법
유산균을 먹는 방법은 딱히 기준이 있는 것은 아닙니다. 하지만 식사 전 2시간 전에 먹어 주는 것이 좋습니다.
성인: 아침 식전에 미지근한 물과 함께 복용
유아: 물이나 분유에 적당하게 타서 복용
가능하다면 유산균의 먹이가 되는 프리바이오틱스(식이섬유 등)와 함께 먹어 주는 것이 좋습니다. 채소에는 식이섬유가 많기 때문에 유산균 활동에 도움이 됩니다. 최근에 유산균과 먹이가 되는 프리바이오틱스가 함께 제공되는 '신바이오틱스'가 출시되었습니다.
실험에 의하면 식전에 섭취하는 것이 식후에 섭취하는 것보다 높은 생존율을 보였다고 합니다. 또한 우유와 함께 먹을 가장 많은 생존률을 보였다고 합니다. 정리하면 이렇네요.
식전 30분, 우유와 함께 먹기
이상으로 여에스더 유산균에 대해 알아봤습니다. 개인적으로 즐겨 먹는 것이라 추천하고 싶네요. 건강한 생활 습관을 통해 육적으로 영적으로 건강한 생활 하시기 바랍니다.
구입처는 여에스더몰과 쿠팡을 추천드립니다. 여에스더 몰에 추천 아이디 입력하시면 3000포인트를 추천자와 가입가 함께 받을 수 있습니다.
추천인 ID: jhenugi
여에스더몰
에스더몰
본사직영, 여에스더 박사의 건강 철학이 담긴 한국인을 위한 맞춤 건강기능식품, 유산균
www.esthermall.co.kr
쿠팡 여에스더 유산균 구입처
[ahc비타민샵][에스더포뮬러] 울트라 플로라 프로바이오틱스 클래식 (60캡슐) x 2병
COUPANG
www.coupang.com
“파트너스 활동을 통해 일정액의 수수료를 제공받을 수 있음"
'일상이야기' 카테고리의 다른 글
| 해외인증 한국소비자원 신고 스미싱(Smishing) (0) | 2021.01.04 |
|---|---|
| 들풀교회 (0) | 2020.12.18 |
| 고신대학교 (0) | 2020.11.08 |
| 전국 신학대학교 종류와 순위 (5) | 2020.11.06 |
| 알잘딱깔센 뜻 (0) | 2020.09.27 |
댓글